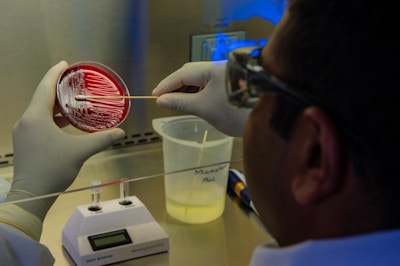
A scientist is handling a petri dish with a red agar medium, using a swab to transfer or culture bacteria in a laboratory setting. The person is wearing gloves for safety and precision. Laboratory equipment is visible, including a container and an electronic instrument in the background.

Veterinary Semen
Explore our extensive collection of quality veterinary semen and equipment.












Contact Us for Veterinary Semen Inquiries
Reach out for all your veterinary semen and equipment needs.



















Explore our extensive collection of quality veterinary semen and equipment.

Reach out for all your veterinary semen and equipment needs.

